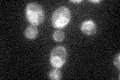
YJL062W

View description
Integral plasma membrane protein involved in the synthesis of the glycosylphosphatidylinositol (GPI) core structure; mutations affect cell wall integrity
Localization:
Intensity:
Fold change:
Significance:
-
C’ GFP library in SD

ER28.54 -
N' NOP1pr-GFP in SD

ER68.3376 -
N' TEF2pr-mCherry in SD

ER22.1239 -
N' NATIVEpr-GFP in SD

ER24.4296 -
N' TEF2pr-VC and Cyto-VN in SD

#N/A0 -
C’ GFP library in SD+DTT

ERN/AN/ANo -
C’ GFP library in SD+H2O2
ER26.430.92No -
C’ GFP library in Starvation Media

ER24.40.85No -
C’ GFP library on the background of Pup2-DaMP

ER -
C’ GFP library on the background of CCT mutant

ER18.97430.664723Yes
